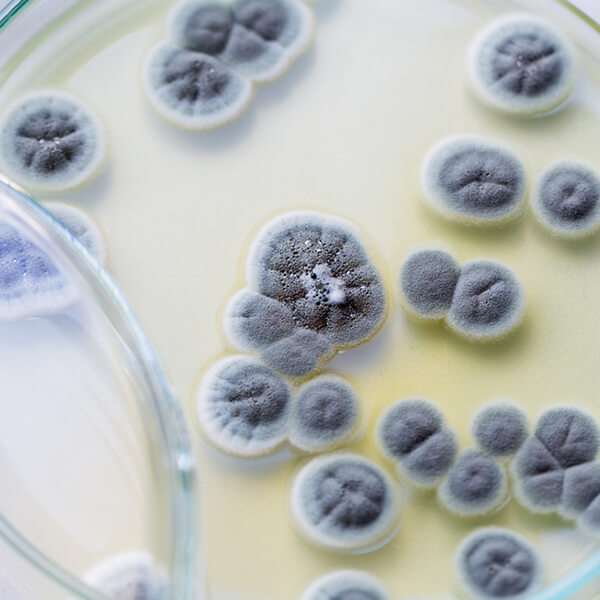
Imagen: Curso internacional en actualización y puesta al día en micología

136 disponibles

Curso online internacional: 50 Horas
Curso internacional en educación para la salud. Pautas actuales

Curso online internacional: 75 Horas
Curso internacional en nuevos métodos y programas en educación para la salud

Curso online internacional: 35 Horas
Curso internacional en el proceso analítico integral de muestras urinarias
Curso online internacional: 35 Horas
Curso internacional en actualización y puesta al día en micología

Curso online internacional: 55 Horas
Curso internacional en el proceso analítico en microbiología clínica

Curso online internacional: 100 Horas
Curso internacional en actualización en hematología y bioquímicas clínicas

Máster Online Internacionales: 1500 Horas, 60 Créditos ECTS
Máster en nutrición, dietética y seguridad alimentaria

Experto Internacional: 750 Horas, 30 Créditos ECTS
Experto internacional en oncología

Curso online internacional: 38.5 Horas
Curso internacional en infecciones bacterianas relacionadas con la asistencia sanitaria

Curso online internacional: 40 Horas
Curso internacional en principios de la práctica clínica basada en la evidencia

Curso online internacional: 40 Horas
Curso internacional en psicooncología básica para el personal de salud

Curso online internacional: 100 Horas, 10.7 Créditos



